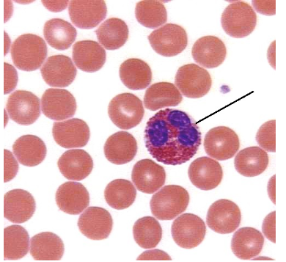
<p><span style="line-height: 17.375px;">Identify the blood cell shown here.&nbsp;</span></p>
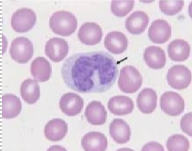
<p><span style="line-height: 17.375px;">Identify the white blood cell shown here.&nbsp;</span></p>

1/160
Looks like no tags are added yet.
Name | Mastery | Learn | Test | Matching | Spaced | Call with Kai |
|---|
No analytics yet
Send a link to your students to track their progress
Trace the pathway of sperm as it leaves the epididymis to exit the body.
1. Ductus deferens, 2. Ejaculatory duct, 3. Prostatic urethra, 4. Membranous urethra, 5. Spongy Urethra, 6. External urethral oriface
Where is sperm produced?
seminiferous tubules
Put the flow of blood in the correct order, starting with the right atrium.
1. Right atrium, 2. Tricuspid valve, 3. Right ventricle, 4. Pulmonary semilunar valve, 5. Pulmonary circuit, 6. Left atrium, 7. Bicuspid valve, 8. Left ventricle, 9. Aortic semilunar valve, 10. Systemic circuit
Which of the following is responsible for the "dubb" sound?
closing of semilunar valves
Which vessel distributes oxygenated blood to the myocardium?
coronary artery
During which of the following events of the cardiac cycle are the AV valves open while the semilunar valves are closed?
quiescent period
Which electrical events occur during the QRS-complex?
ventricular depolarization
Which of the following shows the correct sequence of electrical conduction through the heart?
SA node, AV node, AV bundle, L&R bundle branches, Purkinje Fibers
The difference between systolic and diastolic pressures is known as:
pulse pressure

On an EKG, the P wave indicates which of the following electrical events?
atrial depolarization
Blood that exits the right ventricle will pass through which of the following valves?
pulmonary semilunar valve
Which of the following vessels empties into the right atrium? (please select all that apply)
coronary sinus
inferior vena cava
superior vena cava
On an EKG, ventricular repolarization is represented by the:
T-wave
The blood from the pulmonary veins travels to the:
left atrium of the heart
Where does implantation typically occur?
endometrium
Put in correct order the path feces takes as it exits the body.
1. Cecum, 2. Ascending colon, 3. Right colic flexure, 4. Transverse colon, 5. Left colic flexure, 6. Descending colon, 7. Sigmoid colon, 8. Rectum
Which of the following serves as a passageway for air, food, and water?
pharynx
Which layer of serous membrane lines the abdominal wall?
parietal peritoneum
Where is bile produced?
Liver
Put in correct order the path urine takes as it exits the body.
1. Collecting duct, 2. Minor calyx, 3. Major calyx, 4. Renal pelvis, 5. Ureter, 6. Urinary bladder, 7. Urethra
Where does filtration take place?
renal corpuscle
Put the structures in the correct order of urine formation.
1. Bowman's capsule, 2. Proximal convoluted tubule, 3. Loop of Henle, 4. Distal convoluted tubule, 5. Collecting duct
The walls of bronchi are supported by bands of cartilage and smooth muscle, while the bronchioles only contain smooth muscle.
True
What is the name of the cartilage that forms the Adam's apple?
thyroid cartilage
The layer of serous membrane that touches the lungs is the:
visceral pleura
A flap of cartilage at the root of the tongue, which is depressed during swallowing to cover the opening of the windpipe.
Epiglottis
Trace the pathway air takes as it passes through the larynx and moves towards the lungs
1. Trachea, 2. Primary bronchi, 3. Secondary bronchi, 4. Tertiary bronchi, 5. Bronchioles, 6. Alveoli
Which volumes must be added together to obtain vital capacity?
Tidal volume, Inspiratory reserve volume, Expiratory reserve volume
Which of the following is NOT part of the respiratory zone?
Terminal bronchioles
In which of the following does gas exchange occur?
Alveoli
How many secondary (lobar) bronchi does a human have?
5
Your patient has type AB- blood. What antigens are present on the surface of their erythrocytes?
A and B
Which blood type is the universal recipient?
AB+
What is the most numerous agranulocyte in the blood?
lymphocyte
What is the most numerous leukocyte in the blood?
Neutrophil
Your patient has type O blood. What antibodies are present in their plasma?
anti-A and anti-B
What is the most abundant formed element in the blood?
erythrocytes
You are given a blood type testing sample. It shows agglutination in the Rh well only. Identify the blood type.
O+
During a parasitic infection, you would expect to see an increase in the number of _______________.
eosinophils
Which hormone has the following function:
antidiuretic hormone
Which of the following is a hydrophilic hormone?
oxytocin
Low blood glucose levels would trigger the release of which hormone?
Glucagon
High levels of calcium in the blood would promote the release of which hormone?
calcitonin
The primary function of this hormone is to promote milk production.
prolactin
Where is follicle-stimulating hormone produced?
Anterior Pituitary
What is the function of the hormone produced in the zona glomerulosa of the adrenal cortex?
regulation of salt and water balance
Endocrine gland that produces a variety of hormones, including adrenaline and the steroids aldosterone and cortisol.
Adrenal gland
Which of the following hormones is not produced in the hypothalamus?
Thyroid stimulating hormone
Which of the following arteries DOES NOT directly connect to the aorta. (human)
R common carotid artery
True or false, pulmonary veins carry deoxygenated blood to the left atrium.
False
Put the following in the order a red blood cell takes as it travels from the left ventricle.
1. Artery, 2. Arteriole, 3. Capillary, 4. Venule, 5. Vein
Which of the following blood vessels does not carry oxygenated blood?
Brachiocephalic vein
Coronary sinus
Pulmonary arteries
Vena cava
Which of the following veins DOES NOT drain directly into the inferior vena cava?
Hepatic portal vein

Identify this structure:
spermatic cord

Identify the structure marked with a "5"
Seminal vesicle

Identify the structure marked with a white asterisk.
Prostate gland

Which letter correctly identifies the head of the epididymis?
A

Correctly identify the corpus spongiosum.
D

Identify the valve
aortic semilunar valve

Identify the structures
papillary muscles

Identify the blood vessels shown here.
Left pulmonary veins

Identify the structure
Interventricular septum

Identify the Chamber
Left atrium

Identify the blood vessel shown here.
Left common carotid artery

Identify
cervix

Identify the ligament
Ovarian ligament

Identify
infundibulum of uterine tube

Identify the ligament
Broad ligament

Identify
Lactiferous sinus

Correctly identify the cystic duct
B

Identify the sphincter
Pyloric sphincter

Which letter correctly identifies the hepatic flexure?
A

Which letter correctly identifies the common bile duct?
D

Identify
Diaphragm

Identify
renal column

Identify
urethra

Identify
renal pyramid

Correctly identify the proximal convoluted tubule.
B

Correctly identify the glomerulus.
C

Correctly identify the internal urethral sphincter.
C

Correctly identify the afferent arteriole.
A

Which letter correctly identifies the palatine tonsil?
B

Which letter correctly identifies the nasopharynx?
B

Which letter correctly identifies expiratory reserve volume?
C

Which layer contains white blood cells and platelets?
B
Identify the blood cell shown here.
neutrophil
Identify the white blood cell shown here.
monocyte

Which hormone is produced here?
Thyroid-Releasing Hormone

Which hormones are produced here?
Estrogen, Progesterone, Testosterone

Identify
Infundibulum

Identify the blood vessel.
Common iliac vein

Correctly identify the L. subclavian vein.
C

Identify.
Superior mesenteric artery

Identify the blood vessel.
Femoral artery

Identify the blood vessel.
Left axillary artery

Identify the blood vessel.
Right brachiocephalic vein

Correctly identify the celiac trunk.
A

Identify the structure marked "2."
Clitoris
Each kidney is composed of more than a million complete urinary functional units called:
Nephrons
The specific gravity of urine is ________________ that of water.
greater than